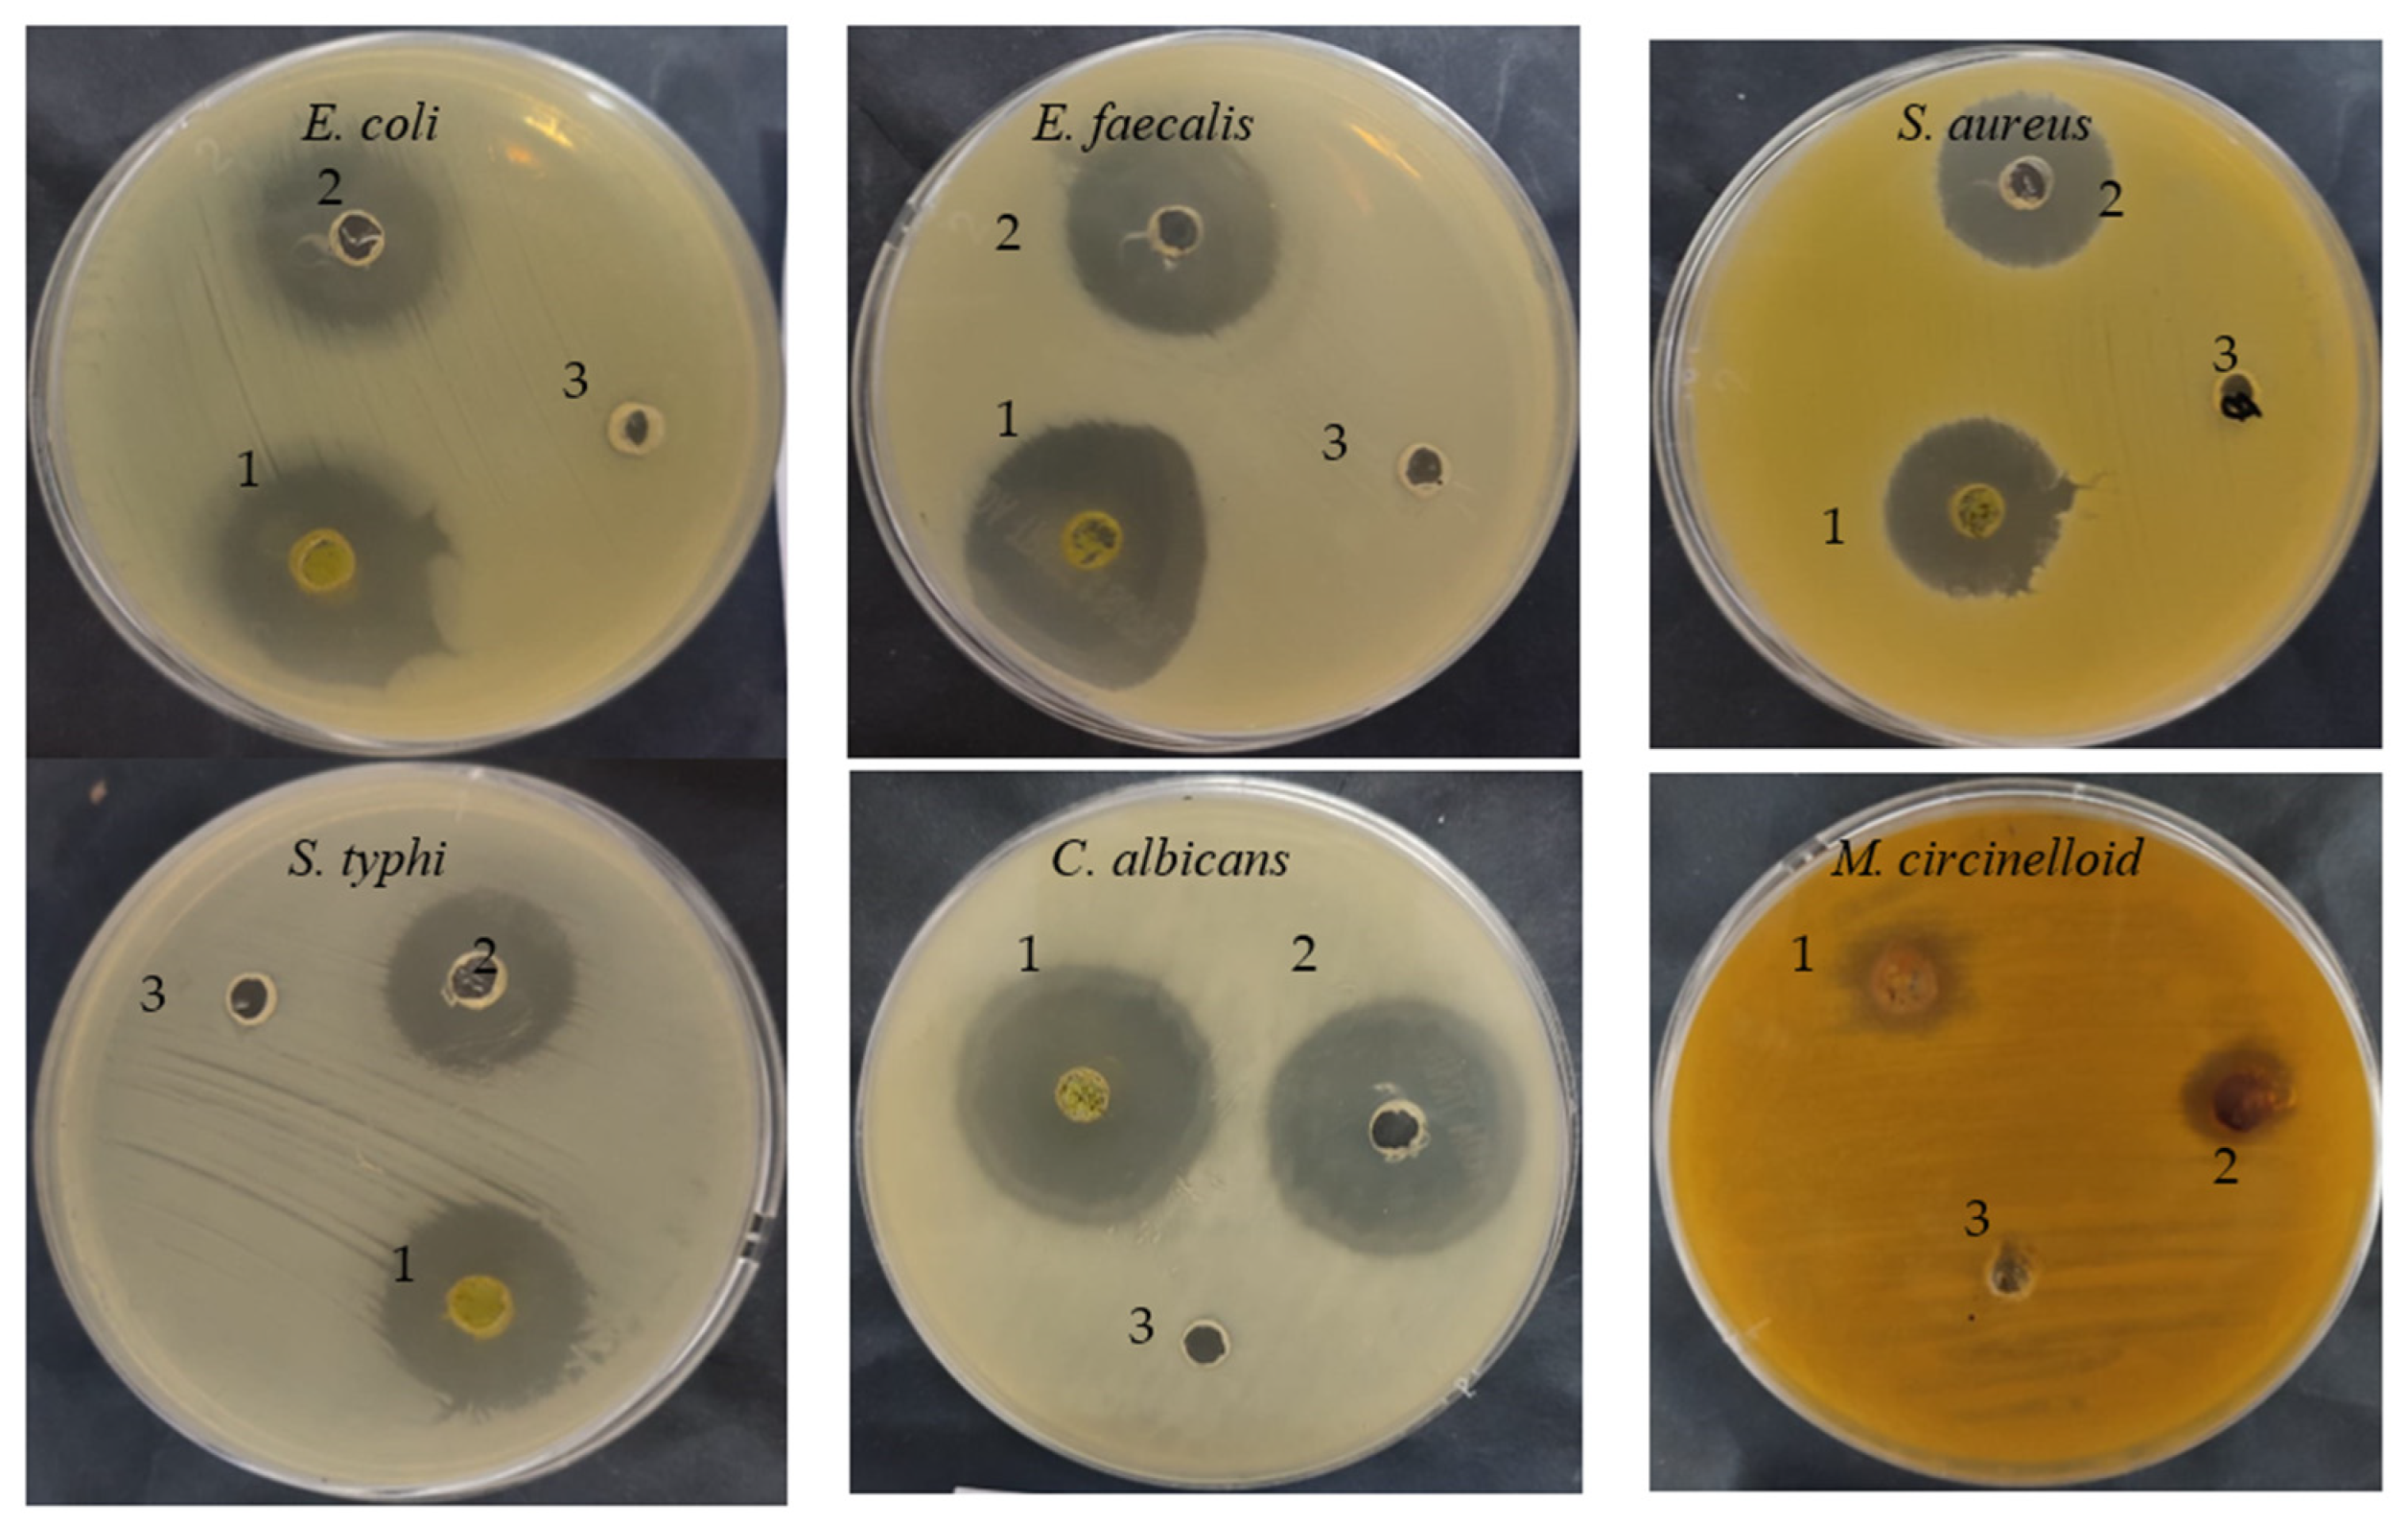
Molecules 28 07402 g003

Abstract
In the last decade, the urgent need to explore medicinal plants or drug development has increased enormously around the world to overcome numerous health problems. In the present investigation, HPLC indicated the existence of 18 phenolic and flavonoid compounds in the Cupressus sempervirens extract. Hesperetin represents the greatest concentration (25,579.57 µg/mL), while other compounds, such as pyro catechol, rutin, gallic acid, chlorogenic acid, naringenin, and quercetin, were recognized in concentrations of 2922.53 µg/mL, 1313.26 µg/mL, 1107.26 µg/mL, 389.09 µg/mL, 156.53 µg/mL, and 97.56 µg/mL, respectively. The well diffusion method documented the antibacterial/antifungal activity of C. sempervirens extract against E. faecalis, E. coli, C. albicans, S. typhi, S.aureus, and M. circinelloid with 35, 33, 32, 25, 23, and 21 mm inhibition zones, respectively, more than the standard antibiotic/antifungal agent. Low values ranging from 7.80 to 15.62 µg/mL of MIC and MBC were recorded for E. faecalis, E. coli, and C. albicans. From the 1- diphenyl-2-picryl hydrazyl (DPPH) assay, promising antioxidant activity was recorded for C. sempervirens extract with IC50 of an 8.97 µg/mL. Moreover, ferric reducing antioxidant power (FRAP) and total antioxidant capacity assays (TAC) confirmed the antioxidant activity of the extract, which was expressed as the ascorbic acid equivalent (AAE) of 366.9 ± 0.2 µg/mg and 102 ± 0.2 µg/mg of extracts, respectively. α-amylase and α-glucosidase inhibition % were determined to express the antidiabetic activity of the extract in vitro, with promising IC50 value (27.01 µg/mL) for α-amylase compared to that of acarbose (50.93 µg/mL), while IC50 value of the extract for α-glucosidase was 19.21µg/mL compared to that of acarbose 4.13 µg/mL. Prothrombin time (PT) and activated partial thromboplastin time (APTT) revealed the role of C. sempervirens extract as an anticoagulant agent if compared with the activity of heparin. Binding interactions of hesperetin and gallic acid were examined via the Molecular Operating Environment (MOE) Dock software against E. faecalis (PDB ID: 3CLQ), C. albicans (PDB ID: 7RJC), α-amylase (PDB ID: 4W93), and α-glucosidase (PDB ID: 3TOP). The obtained results shed light on how molecular modeling methods might inhibit the tested compounds, which have the potential to be useful in the treatment of target proteins.
1. Introduction
Today, drug development or discovery is emphasized by scientific researchers to overcome multidrug-resistance microorganisms and dispersed diseases, which are considered global problems. A wide variety of phytoconstituents play numerous biological functions [1,2,3,4,5]. Cupressus sempervirens is an evergreen tree, one of the traditional aromatic and medicinal plants that contain a wide range of bioactive metabolites. It belongs to the Cupressaceae family, and it is a species of cypress native to the eastern Mediterranean region. Phytochemical screening of C. sempervirens indicated the existence of several classes of chemical compounds, such as phenols, flavonoids, alkaloids, and terpenoids [6]. As mentioned by Selim et al. [7], analysis of constituents indicated the presence of 0.7% alkaloids, 0.22% flavonoids, 0.31% tannin, 1.9% saponins, and 0.067% phenols besides some essential oils with several other biologically active compounds from C. sempervirens. Several pharmacological applications were associated with C. sempervirens extract, such as memory improvement, neuroprotection [8], stimulation of venous circulation to the area of the bladder and kidney, and elimination of fluid retention [9], as well as having antibacterial, antiparasitic, antifungal, antioxidant, antiviral, insecticidal, wound healing, anticoagulant, anticancer, and estrogenic properties [10]. Moreover, it was used for the treatment of neurodegenerative disorders and diabetes mellitus type 2 [11]. Additionally, the antileishmanial potential of C. sempervirens extract was reported against different forms, including amastigote and promastigote of Leishmania major and L. infantum [12]. Anticancer activity either in vitro or in vivo with large antiproliferative activity [13], astringent, antiinflammatory, aromatherapeutic, antispasmodic, antiperspirant, and diuretic properties [14] of C. sempervirens extract was documented.
C. sempervirens reflected antimicrobial activities, but the solvent used represents one of the most important factors that affects the level of the inhibitory potential of the C. sempervirens extract. For instance, Selim et al. [7] reported strong antibacterial activity but not antiyeast activity using methanolic C. sempervirens extract, while ethanolic extract showed moderate antibacterial activity. Moreover, Klebsiella pneumoniae was the most sensitive to methanolic extract with complete killing of bacterial cells when exposed to 250/500 μg/mL at 30/120 min using ethanolic/ethanolic extract. Azzaz et al. [15] mentioned the inhibitory potential of cypress oil against two fungi, Verticillium and Aspergillus. Different microorganisms were exposed to the essential oil of C. sempervirens, some of which, including Escherichia coli, Staphylococcus aureus, Bacillus subtilis, Aspergillus niger, and Candida albicans, were inhibited, but with different inhibition levels, where Bacillus subtilis was found to be the most susceptible, while E. coli was resistant, and a moderate effect was observed on Staphylococcus aureus, Candida albicans, and Aspergillus niger [16]. Previously, Asgary et al. [17] focused on the antioxidant power of chloroformic and methanolic extracts of C. sempervirens. Furthermore, Shahid et al. [18] have documented the antioxidant potential of C. sempervirens leaves extracted by methanol. Recently, Galovičová et al. [19] reported several biological activities of the essential oil extracted from C. sempervirens, such as antibacterial (against Pseudomonas aeruginosa, Salmonella enterica, Yersinia enterocolitica, Bacillus subtilis, Enterococcus faecalis, and Staphylococcus aureus) antifungal (against Candida krusei, C. albicans, C. tropicalis, C. glabrata, Penicillium citrinum, Aspergillus flavus, and Botrytis cinerea), antioxidant, and anticancer. Computational approaches are currently an imperative tool for providing information about the action mechanisms of biologically active compounds. From this approach, molecular docking, which permits the user to dock the active constituents with the active site of the target in the living system [3]. Molecular Operating Environment (MOE), a powerful molecular visualization software and considered a molecular modeling program, is particularly designed to deal with numerous biological compounds. Moreover, it is applied to predict the binding sites and docking score. The root-mean-square deviation (RMSD) is used to detect the differences among true or predicted values of biological compounds. Furthermore, the fields of RMSD and RMSD-refine were applied to compare the results pose-with-pose in the co-crystal ligand position before and after amendment, respectively [1,3]. In the current decade, molecular docking studies have attracted the attention of biologists to assess the affinity of any natural or chemical molecules in relation to a particular biological target. Moreover, it permits decreasing the time and minimizing the cost that required to perform the same biological activity mechanisms [15,16]. The natural constituents originating from plants can be repurposed by these approaches to prove their applications [20]. This investigation aimed to assess the antimicrobial, antidiabetic in vitro and in silico, antioxidant, and anticoagulant potential of C. sempervirens extract.
2. Results and Discussion
2.1. Phytochemical Characterization of C. sempervirens Extract
In the current investigation, the C. sempervirens plant was extracted and subjected to phenolic and flavonoid analysis via HPLC, with multiple biological utilizations as summarized in Figure 1. From HPLC analysis, 18 compounds associated with phenolics and flavonoids were detected in the C. sempervirens extract. The detected compounds differed in retention time, area, area %, and concentration (Table 1 and Figure 2). A promising concentration (25,579.57 µg/mL) of hesperetin was recognized in the C. sempervirens extract, followed by pyro catechol (2922.53 µg/mL), rutin (1313.26 µg/mL), and gallic acid (1107.26 µg/mL). Other important constituents were identified, such as chlorogenic acid (389.09 µg/mL), naringenin (156.53 µg/mL), rosmarinic acid (145.71 µg/mL), and quercetin (97.56 µg/mL). The concentration of ferulic acid in the C. sempervirens extract was low (11.53 µg/mL); at the same time, ellagic acid was injected as a standard in HPLC but not detected in the C. sempervirens extract. Previous results revealed the existence of ten flavonoids with high quantities in C. sempervirens leaves extracted by ethyl acetate such as narengin, hesperetin, quercetrin, and rutin, besides 24 phenolic compounds with a high quantity of vaniliic, coumaric, salicylic, ferulic, and pyrogallol [21], while the present investigation showed less number of detected compounds, may be due to the extraction solvent, climatic, and nutrient conditions of the cultivated plant. The identified compounds in the C. sempervirens extract possess numerous biological activities, as mentioned in previous reports [22,23,24,25,26,27]. For instance, naringin exhibited antiinflammatory and antioxidant activities [22]. Proliferation of several cancer cells such as breast, prostate colon, and lung were prevented using rutin [23]. Srivastava et al. [24] demonstrated the anticancer activity of quercetin. Multi-functions were reported to chlorogenic acid, such as liquefy blood clot [25], hypoglycemic antioxidant, and antiinflammation [26]. In the present study, kaempferol was detected in the C. sempervirens extract, and as mentioned previously [27], it acts as an antioxidant by decreasing oxidative stress as well as improving the efficacy of insulin via decreasing insulin resistance and preserving the shape and activity of pancreatic β-cell.
Figure 1.
Diagrammatic form illustrating experienced processing on C. sempervirens. This shape was generated via BioRender.com. (accessed on 30 May 2023).
Table 1.
Components of flavonoids and phenolics identified in the C. sempervirens extract.
Figure 2.
C. sempervirens extract chromatogram analysis by HPLC for phenolic and flavonoid detection.
2.2. Antimicrobial Activity of C. sempervirens Extract
The C. sempervirens extract demonstrated antibacterial/antifungal activity against various bacteria/fungi (Table 2 and Figure 3), but with different levels of inhibition zone (IZ) depending on the microbial species. For instance, E. faecalis was the most sensitive (35 mm IZ), followed by E. coli (33 ± 0.2 mm IZ), C. albicans (32 ± 0.2 mm IZ), S. typhi (25 ± 0.1 mm IZ), S. aureus (23 ± 0.4 mm IZ), and M. circinelloid (21 ± 0.2 mm IZ). These differences may be due to cell wall composition, the presence of capsules, the ability of microorganisms to produce biofilm, and genes responsible for resistance to antimicrobial agents. Additionally, the microbial inhibitory potential of our collected plant may differ from other studies, where the phytoconstituents and biological activities may differ in the same species of plant depending on cultivation area, climatic conditions, and nutritional conditions. Sriti et al. [28] investigated the essential oil contents, antioxidant, and antimicrobial activities of C. sempervirens L. collected from three regions, including Bizerte, Ben-Arous, and Nabeul. The plant collected from Bizerte and Ben Arous possesses a higher content of essential oils (0.56%), followed by the plant collected from Nabeul (0.49%). High antioxidant activity was attributed to the essential oil of collected plant from Bizerte with an IC50 value of 55 µg/mL, followed by essential oil of the plant collected from Ben-Arous with an IC50 value of 97.50 µg/mL and Nabeul with an IC50 value of 155 µg/mL. The essential oil of the plant collected from Bizerte was the most effective against E. faecalis, with a 65 mm of inhibition zone. In the current research, the inhibitory potential of C. sempervirens extract was greater than the inhibitory potential of standard antibiotic and antifungal agents against all tested microorganisms. The MIC and MBC values were lower for E. faecalis, E. coli, and C. albicans, ranging from 7.80 ± 0.5 to 15.62 ± 1.33 µg/mL, while the MIC and MBC against S. aureus were 125 µg/mL. On the other hand, the values of MIC and MBC against M. circinelloid were high, i.e., 125 ± 3.0 and 500 ± 5.0 µg/mL, respectively. Therefore, from the values of MIC/MBC index, it is clear that C. sempervirens extract reflected cidal effects against tested organisms, except M. circinelloid, because all values were less than 4. The ethyl acetate extract of C. sempervirens flowers exhibited antibacterial activity against Bacillus cereus with an MIC of 100 μg/mL and S. aureus with an MIC of 50 μg/mL [12]. Recently, Yazdani et al. [29] studied the effect of C. sempervirens extracted by methanol on various bacteria; they reported that MIC and MBC were 125 μg/mL and 250 μg/mL against S. aureus; 250 mg/mL and 500 μg/mL against B. cereus, respectively. The differences among our results and the findings of other investigators may be explained according to the different origins of C. sempervirens extract and its acquisition technique.
Table 2.
Antimicrobial activity, MIC, MBC, and MIC/MBC index of the C. sempervirens extract.
Figure 3.
Antimicrobial activities of C. sempervirens extract (1), antibiotic/antifungal (2), negative control (3).
2.3. Antioxidant Activity of C. sempervirens Extract
The free radical-scavenging potential of the tested extract and ascorbic acid as a positive control are illustrated in Figure 4. In fact, C. sempervirens extract increased the inhibition of scavenging % with effectiveness IC50 of 8.97 µg/mL compared to the IC50 value of ascorbic acid (2.43 µg/mL). Previously, C. sempervirens essential oils exhibited antioxidant activity with an IC50 of 151 µg/mL using DPPH [30]. The existence of constituents with diverse functional groups in extracts, besides the analytical technique utilized can lead to differing results. The appeared antioxidant potential of C. sempervirens extract by different protocols indicated that the natural constituents of the extract work synergistically to create a wide range of antioxidant properties. The methanolic extract of C. sempervirens cultivated in Egypt possessed strong DPPH radical-scavenging potential, as described previously [16]. On the contrary, the methanolic extract of C. sempervirens cultivated in Turkey had a moderate scavenging activity [8], which might be depending on their flavonoid and phenolic content. Different extraction solvents of C. sempervirens including methanol, chloroform, ethylacetate, and hexane exhibited antioxidant activities, but with different IC50 values of 39.25, 105.63, 64.07, and 85.62 µg/mL, respectively [31]. The antioxidant activity of the extract was documented also by FRAP, which expressed as ascorbic acid equivalent (AAE) 366.9 ± 0.2 µg/mg (data not tabulated) through standard curve of ascorbic acid (Figure 5). As mentioned previously, the reducing properties are linked with the occurrence of constituents, which appear to have their action via hydrolyze the free radical chain across the offering atom of hydrogen [32]. This suggested the existence of inhibiting constituents because of FRAP activity in the current extract of C. sempervirens. Another method via TAC confirmed the antioxidant activity of C. sempervirens extract, which was expressed as ascorbic acid equivalent (AAE) 102 µg/mg of extract (data not tabulated) through the standard curve of ascorbic acid (Figure 5).
Figure 4.
Antioxidant activity of C. sempervirens extract using DPPH assay.
Figure 5.
Standard curve of ascorbic acid.
In the current investigation, the antioxidant activity of C. sempervirens extract may be due to the occurrence of numerous phenolic and flavonoid compounds, as shown via HPLC analysis. Therefore, according to published investigations, a greatly positive association among the phenolic compounds and antioxidant potential seems to be the trend in several species of plants [33,34,35,36]. Flavonoids may capture peroxide, superoxide, and hydroxyl radicals, which may be one of the mechanisms of oxidative damage prevention or repress the proteins responsible for the formation of free radicals. Antioxidant activity of C. sempervirens extract using eight solvents was recorded [21], where DPPH scavenging potential ranged from 8.75% to 95.43%. Therefore, in the same study, C. sempervirens extract was applied to minimize hepatotoxicity and oxidative damage in rat’s liver. Zengin et al. [11] showed that C. sempervirens exhibited excellent antioxidant power compared to other studied plants, including Artemisia absinthium and Lippia triphylla.
2.4. Antidiabetic Activity of C. sempervirens Extract
Currently, the management of diseases such as diabetes by pharmaceutical plants is recommended due to their high contents of various saponins, flavonoids, terpenoids, alkaloids, carotenoids, and glycosides, which may enjoy antidiabetic properties. The height of glucose levels in the blood and hyperglycemia are greatly affected by the extent of some oxidative enzymes, including α-glucosidase and α-amylase. These enzymes encourage the metabolic reactions responsible for the analysis of complex saccharides into simple sugars such as glucose and its metabolized rate [22]. The antidiabetic potential of the C. sempervirens extract was evaluated by measuring α-amylase (Figure 6) and α-glucosidase (Figure 7) inhibition percentages. The inhibition of both α-amylase and α-glucosidase was increased with increasing the tested quantity of the extract. At concentrations from 62.5 up to 1000 µg/mL of the extract, negligible differences between α-amylase and α-glucosidase inhibition appeared, where the inhibition was 58.7 ± 1.33 and 59.9 ± 1.2% at 62.5 µg/mL; 70.3 ± 2.66 and 70.5 ± 0.75% at 250 µg/mL; and 82.5 ± 2.25 and 81.9 ± 1.00% at 1000 µg/mL, respectively. While at low concentrations of 1.95 up to 31.25 µg/mL, remarkable differences were visualized between α-amylase and α-glucosidase inhibition, where the inhibition was 26.0 ± 0.33 and 31.3 ± 0.50% at 1.95 µg/mL; 31.8 ± 1.33 and 36.7 ± 0.78% at 3.91 µg/mL; and 51.9 ± 1.5 and 54.9 ± 1.65% at 31.25 µg/mL, respectively. Surprisingly, the IC50 value of the extract (27.01 ± 1.0 µg/mL) was lower than that of acarbose (50.93 ± 0.5 µg/mL) for α-amylase, while the IC50 value of the extract (19.21 ± 0.33 µg/mL) was more than that of acarbose (4.13 ± 0.25 µg/mL) for α-glucosidase. These results indicated the presence of different mechanisms of enzyme inhibition by the extract and acarbose. However, generally, from the obtained findings, the IC50 values of the extract indicated its antidiabetic properties. Moreover, the differing IC50 value of C. sempervirens extract for enzymes inhibition in our study may be due to explanation of Truscheit et al. [33], as mentioned previously, who stated that α-amylase generally joined longer than α-glucosidase with polysaccharides, and acarbose is a pseudotetrasaccharide comprising a non-hydrolyzable nitrogen-jointed bond that represses the activity of α-amylase via competitive as reversible represses. According to the results of Shaki et al. [34], the reduction of glucose in the blood and the management of diabetes have occurred using C. sempervirens extract. C. sempervirens among two plants, including Artemisia absinthium and Lippia triphylla [11], caused the highest inhibition of α-amylase and α-glucosidase.
Figure 6.
Antidiabetic properties of C. sempervirens extract via measuring α-amylase.
Figure 7.
Antidiabetic properties of C. sempervirens extract via measuring of α-glucosidase.
2.5. Anticoagulant Activity of C. sempervirens Extract
There is a remarkable increment in the clotting time of PT and APPT values of plasma treated with the C. sempervirens extract at all tested concentrations (Figure 8 and Figure 9), where at 25, 50, and 75 µg/mL, the clotting time was 25.3 ± 0.29, 44.9 ± 1.0, and 90.5 ± 2.55 s of PT (Figure 8), and 41 ± 2.05, 63.2 ± 1.33, and 104.1 ± 3.25 s of APPT (Figure 9), respectively. The prolongation of clotting time may support the idea that the influence of C. sempervirens extract activates optimally within a limited dose range. Therefore, prolonged PT and PTT by C. sempervirens extract management propose inhibition of factors V, X, and prothrombin of the common pathway of coagulation. These results, if compared with heparin, are considered very promising in case of the PT test and in the case of the APPT test, where the clotting time was 22.5 ± 0.33, 49.8 ± 1.21, and 99.8 ± 2.66 s for PT, and 66.1 ± 2.3, 93.8 ± 2.15, and 145.7 ±2.33 s for APPT at 25, 50, and 75 µg/mL, respectively (the PTT reference range is 30–40 s, while the reference range of the PTT is 60–70 s). The obtained findings revealed the anticoagulant properties of C. sempervirens extract and may encourage the dissolution of clots. The anticoagulant potential of C. sempervirens extract could be due to the occurrence of some natural compounds as recorded by HPLC analysis in the present investigation. The anticoagulant properties of C. sempervirens were reported to be anticoagulant [14].
Figure 8.
Anticoagulant activity of C. sempervirens extract and heparin at different concentrations via prothrombin time (PT).
Figure 9.
Anticoagulant activity of C. sempervirens extract and heparin at different concentrations via activated partial thromboplastin time (APTT).
2.6. Molecular Docking Interaction of Hesperetin and Gallic Acid with Microbial Proteins, α-Amylase and α-Glucosidase
As mentioned in the phenolic and flavonoid analysis of of C. sempervirens extract via HPLC, some active constituents of C. sempervirens extract, represented by the highest detected flavonoid (hesperetin) and phenolic (gallic acid), were docked with some tested microorganisms protein, including E. faecalis (PDB ID: 3CLQ) and C. albicans (PDB ID: 7RJC), as well as with α-amylase (PDB ID: 4W93) and α-glucosidase (PDB ID: 3TOP), to support the activity of the extract. Several studies applied molecular docking tools to confirm the activity of natural compounds, discover new ones, or design pharmacological compounds for the treatment of numerous diseases [5,20]. The results showed that both ligands studied have a comparable position and orientation inside the putative binding site of proteins, revealing a vast region limited by a membrane binding domain that serves as an entrance conduit for the substrate to the active site (Figure 10, Figure 11, Figure 12, Figure 13, Figure 14, Figure 15, Figure 16 and Figure 17). Furthermore, the affinity of any small molecule can be thought of as a unique instrument in the realm of drug design. The affinity of organic molecules and the free energy of binding have a relationship. This relationship can help anticipate and interpret the activity of organic chemicals towards given target proteins. The selected compounds had favorable binding free energies values in negative Kcal·mol−1 (E_score2), as indicated in Table 3. The proposed binding mode of hesperetin revealed an affinity value of −6.3585, −6.25187, −5.92382, and −5.42187 Kcal·mol−1 towards α-glucosidase (PDB ID: 3TOP), C. albicans (PDB ID: 7RJC), α-amylase (PDB ID: 4W93), and E. faecalis (PDB ID: 3CLQ), respectively. While the proposed binding mode of gallic acid reported an affinity value of −4.69897, −4.61066, −4.47121, and −4.20859 Kcal·mol−1 against 4W93, 3TOP, 7RJC, and 3CLQ, respectively. The obtained results of molecular docking interactions reflected a low energy score with the 3TOP, 7RJC, 4W93, and 3CLQ proteins indicating the vital role of hesperetin for repressing bacteria and enzymes action if compared to energy score in the case of gallic acid. In the study of the binding properties of hesperetin the O 26, O 30, and O 25 atoms form hydrogen bond contact with the ASN110, LYS443, and GLY113 amino acid residues of E. faecalis 3CLQ, respectively. The O 25 atom bonded with the ASP271 amino acid residue of C. albicans 7RJC. The O 26 forms donor hydrogen bond with the ASP317 of α-amylase 4W93. Finally, hesperetin formed three interactions with GLY1309, LYS1306, and ARG1311 of α-glucosidase 3TOP through its O 26, O 28, and O 25 atoms, respectively.

Figure 10.
Molecular docking process of hesperetin with 3CLQ.

Figure 11.
Molecular docking process of gallic acid with 3CLQ.

Figure 12.
Molecular docking process of hesperetin with 7RJC.

Figure 13.
Molecular docking process of gallic acid with 7RJC.

Figure 14.
Molecular docking process of hesperetin with 4W93.

Figure 15.
Molecular docking process of gallic acid with 4W93.

Figure 16.
Molecular docking process of hesperetin with 3TOP.

Figure 17.
Molecular docking process of gallic acid with 3TOP.
Table 3.
Docking scores and energies of hesperetin and gallic acid with structure of E. faecalis 3CLQ, C. albicans 7RJC, α-amylase 4W93, and α-glucosidase 3TOP.
On the other hand, gallic acid inhibits E. faecalis 3CLQ through binding directly the O 17 atom to the essential amino acid inside its pocket (GLY317). The O 11 atom forms hydrogen bond with HIS301 amino acid of C. albicans 7RJC, where O 9 and O 13 undergo hydrophobic contact with ASP317 amino acid residue of α-amylase 4W93. There is a hydrogen bond observed between (O 11, O 13) atoms and (HIS1727, ASP1754) in α-glucosidase 3TOP respectively. Table 4, Table 5, Table 6 and Table 7 illustrate several interactions with amino acids in the target proteins pocket. They were stabilized at the protein binding site by altering multiple electrostatic bonds, which was reflected in the biological activity profile. The binding energy among the active constituents and the target receptor proteins resulted from molecular docking analysis encouragements a possible antimicrobial and antidiabetic role of C. sempervirens extract. Previously, Zengin et al. [11] mentioned that the best docking pose resulted from the docking interaction of apigenin, protocatechuic acid, and chlorogenic acid and catechin as constituents of C. sempervirens extract against the α-glucosidase and α-amylase was mainly stabilized through pi–pi stacks and hydrogen bonds. From recent investigations, ellagic and chlorogenic acids were docked with crystal structures of C. albicans (4YDE) and Geotrichum candidum (4ZZT), where ellagic acid reflected less docking score (−6.19 and −4.51 Kcal/mol) than chlorogenic acid (7.84 and −5.70 Kcal/mol) against G. candidum (4ZZT) and C. albicans (4YDE), respectively [4]. According to Molecular Docking and Molecular Dynamic Simulation analysis, C. sempervirens is an excellent candidate for SARS-CoV-2 virus management [3].
Table 4.
Interaction of hesperetin and gallic acid with structure of E. faecalis 3CLQ.
Table 5.
Interaction of hesperetin and gallic acid with structure of C. albicans 7RJC.
Table 6.
Interaction of hesperetin and gallic acid with structure of α-amylase 4W93.
Table 7.
Interaction of hesperetin and gallic acid with structure of α-glucosidase 3TOP.
3. Material and Methods
3.1. Used Chemicals
Mueller Hinton broth, Sabouraud dextrose broth (MHB, Oxoid, Basingstoke, UK), Acetonitrile, dimethylsulfoxide (DMSO), 2,2-diphenyl-1-picrylhydrazyl (DPPH), methanol (HPLC Grade, purity > 99%), and Mueller–Hinton agar were obtained from Sigma-Aldrich (Steinheim, Germany). Conversely, gentamicin, fluconazole, H2SO4, sodium phosphate (NaH2PO4), ammonium molybdate, potassium ferricyanide, ascorbic acid (American Chemical Society Grade), potato dextrose agar medium, and 3,5-dinitrosalicylic acid (Analytical Grade) were obtained from Active Fine Chemicals Limited, Dhaka, Bangladesh.
3.2. Collection of Plant Material
Aerial parts including leaves and stems of Cupressus sempervirens L. were collected from the garden of El-Orman, Giza, Egypt in august 2023. The collected plant parts were washed with running water, and then dried in air, followed by drying in oven at 50 °C for obtaining constant weight, then powdered, and preserved at 25 °C for phytochemical analysis and further biological activities.
3.3. Determination of Phenolic and Flavonoid Components by HPLC-UV Assay
C. sempervirens extract was subjected to high-performance liquid chromatography (HPLC) for flavonoid and phenolic analysis. HPLC-(Agilent 1100), fortified with two pumps of liquid chromatography, detector of UV/Vis, C18 column (125 mm × 4.60 mm, 5 µm particle size) (Agilent, Santa Clara, CA, USA). The prepared extract (20 µL) was inoculated in HPLC, with using mobile solvents (acetic acid/water, 60:40 v/v) for the separation of phenolic acids. Conversely, methanol/water (50:50 v/v) was used as mobile phase for separation of flavonoids, at rate of 1.0 mL min−1. The gradient linear was serially automated into the mobile phase with the following arrangement: 82% A at 0 min, 80% A at 0–5 min, 60% 5–8 min, 12% at 8 min,1 5% at 12 min, 16% at 15 min, and 20% at 16 min. The wavelength detector was adjusted at 280 nm, with keeping the column at 40 °C during the entire run process. The appeared peaks of phenolic and flavonoid constituents were recorded for the identification of the separated compounds via the comparison of its retention time besides UV-Vis spectra with injected standards compounds.
3.4. Antimicrobial Activity of C. sempervirens Extract
The antimicrobial activity of C. sempervirens extract was ascertained using the well diffusion technique. Each microorganism’s inoculum was made 24 h in advance using Potato dextrose broth for fungi (Candida albicans and Mucor circinelloid) and Mueller Hinton broth for bacteria (Enterococcus faecalis, Staphylococcus aureus, Escherichia coli, and Salmonella typhi). Using a densitometer (BIOSAN, Latvian Republic), the pre-cultured inoculum was adjusted to an optical density of 0.5 McFarland standard at 1.5 × 108 Colony-Forming Units per milliliter (CFU/mL). The inhibition zones resulted from the effect of extract which estimated via measuring of its radii from well edge to zone edge. Dimethyl sulfoxide (0.1%) and 100 µL of 5 µg antibiotic (gentamicin)/antifungal (fluconazole) served as a negative and positive control, respectively. For minimum inhibitory concentration (MIC) detection, Mueller Hinton broth/Sabouraud dextrose broth was used for bacterial/fungal inoculum activation and preparation for 24 h/48 h at 37 °C/25 °C, respectively. With the appropriate broth, the microbial culture was diluted to adjust the inoculum level to an optical density (0.5 McFarland standard). Then, 100 μL of microbial inoculum was inoculated in a 96-well microtiter plate. Via serial dilution, different concentrations of the extract were added to the wells. Media with extract only served as a negative control, while microbial inoculum without extract served as a positive control for obtaining maximum microbial growth. At 570 nm, the absorbance of plates was recorded at 0 h of inoculum time and repeated at the same wavelength after 24 h. Then, the value of MIC was calculated using log it analysis. MIC was recorded for fungal growth via a spread of 100 μL of fungal inoculum (adjusted to 0.5 McF of 1.5 × 108 CFU/mL) on a petri dish containing sabouraud dextrose agar medium. Different concentrations of 7.8 up to 500 μg/mL of the extract were achieved through dilution in DMSO solution (0.1%). In total, 10 μL of each concentration was applied in 6 mm of agar well followed by incubation the fungal culture for 5 days at 25 °C. The zone radii of inhibition (zone without microbial growth around the loaded well with the extract or antimicrobial compounds) were recorded [20]. For measurement of minimum bactericidal concentration (MBC), a pure active selected microbe for overnight was diluted broth MH at 1 × 106 CFU/mL. An inventory dilution of the C. sempervirens extract is made at 100% instances of the MIC. Furthermore, equal volume (1:1 dilutions) is made in 96 microtiter plates. All concentrations of the C. sempervirens extract are injected with equal volumes of the tested microbes. Some wells were used as a positive and negative control for every tested microorganism to reveal acceptable growth over the appropriate incubation period. The possibility of the MBC is detected by the dilution signifying the MIC and at minimum two more concentrated test product dilutions. The lowest dose that displays a pre-defined lessening in CFU/mL is the MBC. The aspects of utilized C. sempervirens extract regarding static or cidal were recorded through the detection the index of MBC/MIC; if the ratio of MBC/MIC is no greater than four intervals of the MIC, the C. sempervirens extract has a cidal value [37].
3.5. Antioxidant Activity of C. sempervirens Extract
3.5.1. DPPH Free Radical Scavenging Test
The capacity of C. sempervirens extract to scavenging the free radical was assessed. In total, 3 mL of DPPH solution (0.1 mM) was added to 0.1 mL of the methanolic extract at different concentrations. At wavelength 515 nm, the absorption was measured. Ascorbic acid was served as standard [36]. The IC50 value (the amount requisite to inhibit 50% of the DPPH free radical) of C. sempervirens extract was computed using a log concentration of inhibition curve. The following Formula (1) was applied to calculate the scavenging capacity of DPPH radical:
3.5.2. Total Antioxidant Capacity Assay (TAC)
Using the phosphomolybdenum technique, the extract was evaluated spectrophotometrically in accordance with the steps outlined by Prieto et al. [38]. Three mL of the reagent solution (0.6 M H2SO4, 28 mM of NaH2PO4, and 4 mM ammonium molybdate) were combined with one mL of each sample extract (0.5 mg/mL). Only 4 mL of reagent solution made up the blank solution. The mixes were incubated for 150 min at 95 °C. Microtiter plate reader (Biotek ELX800; Biotek, Winooski, VT, USA) absorbance at 630 nm was measured when the mixture had reached room temperature. According to Lahmass et al. [39], values were represented as ascorbic acid equivalent (AAE) g/mg of extracts.
3.5.3. Ferric Reducing Antioxidant Power (FRAP) Assay
The potassium ferricyanide and trichloroacetic acid technique [40] was utilized with various modifications and adaption for the microplate method [41] to examine the effect of solvent polarity on the overall reducing power of extracts. Beyond this point, total reducing power (TRP) will be used instead of ferric reducing antioxidant power (FRAP). In total, 40 mL of sample, 50 mL of buffered sodium phosphate dihydrate (Na2HPO4. 2H2O), 50 mL of 1% potassium ferricyanide K3[Fe (CN)6], and 50 mL of 10% trichloroacetic acid were added to each labeled Eppendorf tube. For 10 min, the mixture was centrifuged at 3000 rpm. Following centrifugation, 33.3 mL of ferric chloride (FeCl3, 1%) and 166.66 mL of the supernatant from each sample were put to 96-well plates. Microtiter plate reader (Biotek ELX800; Biotek, Winooski, VT, USA) readings were collected at 630 nm. Ascorbic acid (1 mg/mL) was utilized as a positive control and DMSO as a negative control. The ascorbic acid equivalent (AAE) mg/mg of extract was used to express the results.
3.6. Antidiabetic Activity of C. sempervirens Extract
3.6.1. α-Glucosidase Inhibition
The used extract was tested for α-glucosidase inhibitory activity using a slightly modified version of the procedure described by Pistia-Brueggeman and Hollingsworth [42]. In total, 50 μL of the tested extracts at varied quantities (1.97 to 1000 μg/mL) was mixed with 125 μL of 0.1 M phosphate buffer (pH 6.8) and kept at 37 °C for 20 min with 10 μL of the α-glucosidase solution. In total, 20 μL of 1 M p-nitrophenyl-α-D-glucopyranoside (p-NPG) as enzyme substrate was added to initiate the reaction after 20 min, and the mixture was then kept for 30 min. With the addition of 50 μL of Na2CO3 (0.1 N), the reaction was stopped, followed by measuring the absorbance at 405 nm using a spectrophotometer (Biosystm 310 Plus). α-glucosidase inhibition was calculated via the following Formula (2):
where AE is the absorbance of α-glucosidase without treatment with the extract and AES is absorbance of α-glucosidase treated with the extract.
One unit of the α-glucosidase was defined as the quantity of α-glucosidase necessitated for the creation of one μmol of p-nitrophenol from the p-NPG per minute.
3.6.2. α-Amylase Inhibitory Activity
The used extract was tested for α-amylase inhibitory activity using a slightly modified version of the procedure described by Wickramaratne [43] using 3,5-dinitrosalicylic acid (DNSA) technique. In total, 10% of DMSO were used to dissolve the tested extract, and then it was further dissolved in Na2HPO4 (0.02 M)/NaH2PO4 (0.02 M) and 0.006 M of NaCl adjusted at pH 6.9 as a buffer to obtain ranging concentrations from 1.9 up to 1000 μg/mL. The reaction mixture contained of 200 μL of 2 units/mL of α-amylase with 200 μL of the tested extract, followed by incubation at 30 °C for 10 min. Then, 200 μL of suspended starch in water (1%) was added to the reaction mixture and kept for 3 min. DNSA reagent (200 μL) was added to the reaction mixture (require to stop the reaction) with boiling in a water bath at 90 °C for 10 min. After cooling of the reaction mixture (at 25 °C), it was diluted with 5 mL of distilled H2O. Followed by measuring the absorbance at 540 nm using spectrophotometer (Biosystm 310 Plus). The 100% activity of α-amylase as a control 100% was formulated by alternating the tested extract by 200 μL of buffer, while the blank reaction was formulated utilizing the tested extract without the α-amylase solution. α-amylase inhibition was calculated via the following Formula (3):
where AE is absorbance of α-amylase without treatment (control) with the extract and AES is absorbance of α-amylase treated with the extract.
The concentration extract necessitated to inhibit 50% of the activity of α-glucosidase/α-amylase (IC50, μg/mL) was calculated employing regression equation achieved via plotting concentration ranged from 1.95–1000 μg/mL and developed % inhibition.
3.7. Coagulation Assay of C. sempervirens Extract In Vitro
The anticoagulant activity of C. sempervirens extract was examined via coagulant assays activated partial thromboplastin time (APTT) (unite of time with seconds) and prothrombin time (PT) (time in seconds). Nine/one parts of human blood (from corresponding author of the current paper)/sodium citrate (3.2%) (v/v) were mixed, and then centrifuged for 10 min at 5000 rpm, followed by supernatant collection containing plasma. Different doses (25, 50, and 75 µg/mL) of C. sempervirens extract were dissolved in 0.9% aqueous solution of NaCl. The reaction mixture contained plasma and C. sempervirens extract, and then kept at 37 °C for 3 min. The reagent of APTT (0.10 mL) (previously pre-kept at 37 °C for 3 min) was added to the reaction mixture and then kept at 37 °C for 5 min. Later, 0.10 mL of 0.025 mol/L CaCl2 (pre-kept at 37 °C for 3 min) was added to the reaction mixture, followed by recording clotting time. For PT test, the plasma was mixed with C. sempervirens extract, and then kept at 37 °C for 3 min. The reagent of PT (0.20 mL) (pre-kept at 37 °C for 3 min) was added to the reaction mixture, followed by recording clotting time. The cited method was re-performed with heparin as appositive control and with plasma without C. sempervirens extracts as control [44].
3.8. Experimental Methods of Molecular Docking Interaction
Molecular operating environment (MOE) software on Dell Core i7 processor 1.9 GH, 16 GB memory with Windows 10, 64-bit operating system was used to conduct molecular docking investigations on hesperetin and gallic acid binding properties in E. faecalis (PDB ID: 3CLQ), C. albicans (PDB ID: 7RJC), α-amylase (PDB ID: 4W93), and α-glucosidase (PDB ID: 3TOP). Each protein used downloaded from the Protein Data Bank (http://www.rcsb.org/pdb, accessed on 13 September 2023). At first, the protein files were prepped using built-in “Quickprep” function. Then, water molecules and bound ligands were manually deleted from the downloaded proteins. The file of the prepared protein active site was loaded; the docking site was specified as dummy atoms, the placement methodology as triangle matcher, and the scoring methodology as London dG. The refinement methodology was adjusted as a rigid receptor and the scoring methodology as GBVI/WSA dG for selecting the best 5 poses from 100 different poses for each tested molecule. The library of compounds was imported and prepped into MOE database file and dock calculations were run automatically. At the end of the docking processes, the obtained poses were carefully studied, and the ones having the best ligand–protein interactions with the most acceptable RMSD values were selected.
3.9. Statical Evaluation
The achieved antimicrobial, antioxidant, anticoagulant, and antidiabetic results were obtained in triplicate, so the results were calculated as mean values of ±standard deviation (±SD).
4. Conclusions
Several investigations were planned in the present study, including analytical characterization of phenolic and flavonoid constituents in C. sempervirens extract with the estimation antimicrobial, antidiabetic, antioxidant, and anticoagulant activities. C. sempervirens extract was richened with several phenolic and flavonoid compounds, such as hesperetin (25,579.57 µg/mL), chlorogenic acid (389.09 µg/mL), naringenin (156.53 µg/mL), and quercetin (97.56 µg/mL), which play a vital role in the biosystems. Pathogenic bacteria as well as fungi were inhibited with C. sempervirens extract but with different levels of inhibition depending on the type of microbe ranging from 21 to 35 mm inhibition zone. The values of the MIC and MBC of the extract were low for some microorganisms such as E. faecalis, E. coli, and C. albicans, ranging from 7.80 to 15.62 µg/mL. Antioxidant potential via DPPH, FRAP, and TAC was referred to the antioxidant potential of C. sempervirens extract. Moreover, antidiabetic activity in vitro via measuring α-amylase (with IC50 of 27.01 µg/mL) and α-glucosidase (with IC50 of 19.21µg/mL) inhibition; moreover, anticoagulant through PT and APPT assays were linked to C. sempervirens extract. The molecular design was performed to investigate the binding mode of the proposed compounds with E. faecalis (PDB ID: 3CLQ), C. albicans (PDB ID: 7RJC), amylase (PDB ID: 4W93), and glucosidase (PDB ID: 3TOP). The data obtained from the docking studies were fitted with that obtained from the biological screening. All the tested compounds showed significant inhibitory activities against selected proteins. The obtained results indicated that the active compounds could be useful as a template for future design, optimization, adaptation, and investigation in order to generate more potent and selective inhibitors with higher analogs.
Author Contributions
Conceptualization and writing—review and editing A.M.H.A.-R. and M.M.B.; methodology and writing—review and editing, H.Q. and A.M.H.A.-R.; formal analysis and writing—review and editing, H.H. and M.A.A.; investigation and writing—review and editing T.M.A. and H.Y.A.; resources, H.H. and M.A.A.; writing—original draft preparation, T.M.A. All authors have read and agreed to the published version of the manuscript.
Funding
This research was funded by Princess Nourah bint Abdulrahman University Researchers Supporting Project number (PNURSP2023R217), Princess Nourah bint Abdulrahman University, Riyadh, Saudi Arabia.
Institutional Review Board Statement
Not applicable.
Informed Consent Statement
Not applicable.
Data Availability Statement
Not applicable.
Acknowledgments
To Princess Nourah bint Abdulrahman University Researchers Supporting Project number (PNURSP2023R217), Princess Nourah bint Abdulrahman University, Riyadh, Saudi Arabia.
Conflicts of Interest
The authors declare no conflict of interest.
References
- Mashraqi, A.; Modafer, Y.; Al Abboud, M.A.; Salama, H.M.; Abada, E. HPLC Analysis and Molecular Docking Study of Myoporum serratum Seeds Extract with Its Bioactivity against Pathogenic Microorganisms and Cancer Cell Lines. Molecules 2023, 28, 4041. [Google Scholar] [CrossRef]
- Mashraqi, A. Induction Role of Chitosan Nanoparticles to Anethum graveolens Extract Against Food-Borne Bacteria, Oxidant, and Diabetic Activities in vitro. Front. Microbiol. 2023, 14, 1209524. [Google Scholar] [CrossRef]
- Soudani, W.; Zaki, H.; Alaqarbeh, M.; ELMchichi, L.; Bouachrine, M.; Hadjadj-Aoul, F.Z. Discover the Medication Potential of Algerian Medicinal Plants Against Sars-Cov-2 Main Protease (Mpro): Molecular Docking, Molecular Dynamic Simulation, and ADMET Analysis. Chem. Afr. 2023. [Google Scholar] [CrossRef]
- Alsalamah, S.A.; Alghonaim, M.I.; Jusstaniah, M.; Abdelghany, T.M. Anti-Yeasts, Antioxidant and Healing Properties of Henna Pre-Treated by Moist Heat and Molecular Docking of Its Major Constituents, Chlorogenic and Ellagic Acids, with Candida albicans and Geotrichum candidum Proteins. Life 2023, 13, 1839. [Google Scholar] [CrossRef]
- Qanash, H.; Bazaid, A.S.; Aldarhami, A.; Alharbi, B.; Almashjary, M.N.; Hazzazi, M.S.; Felemban, H.R.; Abdelghany, T.M. Phytochemical Characterization and Efficacy of Artemisia judaica Extract Loaded Chitosan Nanoparticles as Inhibitors of Cancer Proliferation and Microbial Growth. Polymers 2023, 15, 391. [Google Scholar] [CrossRef]
- Mazari, K.; Bendimerad, N.; Bekhechi, C.; Fernandez, X. Chemical Composition and Antimicrobial Activity of Essential Oils Isolated from Algerian Juniperus phoenicea L. and Cupressus sempervirens L. J. Med. Plants Res. 2010, 4, 959–964. [Google Scholar]
- Selim, S.A.; Adam, M.E.; Hassan, S.M.; Albalawi, A.R. Chemical Composition, Antimicrobial and Antibiofilm Activity of the Essential Oil and Methanol Extract of the Mediterranean cypress (Cupressus sempervirens L.). BMC Complement Altern. Med. 2014, 14, 179. [Google Scholar] [CrossRef] [PubMed]
- Tümen, I.; Şenol, F.; Orhan, E.I. Evaluation of Possible In Vitro Neurobiological Effects of Two Varieties of Cupressus sempervirens (Mediterranean cypress) Through Their Antioxidant and Enzyme Inhibition Actions. Turk. J. Biochem-Turk Biyokim. Derg. 2012, 37, 5–13. [Google Scholar] [CrossRef]
- Thukral, S.K.; Singh, S.; Sharma, S.K. Pharmacognostical Standardization of Leaves of Cupressus macrocarpa Hartweg. ex Gordon. J. Appl. Pharmaceut. Sci. 2014, 4, 71–74. [Google Scholar]
- Al-Snafi, A.E. Medical Importance of Cupressus sempervirens-A review. IOSR J. Pharm. 2016, 6, 66–76. [Google Scholar]
- Zengin, G.; Mollica, A.; Aktumsek, A.; Picot CM, N.; Mahomoodally, M.F. In Vitro and In Silico Insights of Cupressus sempervirens, Artemisia absinthium and Lippia triphylla: Bridging Traditional Knowledge and Scientific Validation. Eur. J. Integr. Med. 2017, 12, 135–141. [Google Scholar] [CrossRef]
- Rguez, S.; Essid, R.; Adele, P.; Msaada, K.; Hammami, M.; Mkadmini, K.; Sellami, I.H. Towards the Use of Cupressus sempervirens L. Organic Extracts as A Source of Antioxidant, Antibacterial and Antileishmanial Biomolecules. Ind. Crops Prod. 2019, 131, 194–202. [Google Scholar] [CrossRef]
- Teibo, J.O.; Ayinde, K.S.; Olaoba, O.T.; Adelusi, T.I.; Teibo, T.K.; Bamikunle, M.V.; Batiha, G.E.S. Functional Foods’ Bioactive Components and Their Chemoprevention Mechanism in Cervical, Breast, and Liver Cancers: A systematic review. Funct. Foods Health Dis. 2021, 11, 559–585. [Google Scholar] [CrossRef]
- Batiha, G.E.; Teibo, J.O.; Shaheen, H.M.; Akinfe, O.A.; Awad, A.A.; Teibo, T.K.A.; Alexiou, A.; Papadakis, M. Bioactive Compounds, Pharmacological Actions and Pharmacokinetics of Cupressus sempervirens. Naunyn Schmiedebergs Arch. Pharmacol. 2023, 396, 389–403. [Google Scholar] [CrossRef] [PubMed]
- Azzaz, N.A.; Hamed, S.S.; Kenawy, T.A. Chemical Studies on Cypress Leaves (Cupressus sempervirens) and Their Activity as Antimicrobial Agents. Al-Azhar J. Agric. Res. 2019, 44, 100–109. [Google Scholar] [CrossRef]
- Ibrahim, N.A.; El-Seedi, H.R.; Mohammed, M.M.D. Constituents and Biological Activity of the Chloroform Extract and Essential Oil of Cupressus sempervirens. Chem. Nat. Compd. 2009, 45, 309–313. [Google Scholar] [CrossRef]
- Asgary, S.; Naderi, G.A.; Shams, A.R.; Sahebkar, A.; Airin, A.; Aslani, S.; Emami, S.A. Chemical Analysis and Biological Activities of Cupressus sempervirens var. Horizontalis Essential Oils. Pharm. Biol. 2013, 51, 137–144. [Google Scholar] [CrossRef] [PubMed]
- Shahid, W.; Durrani, R.; Iram, S.; Durrani, M.; Khan, F.A. Antibacterial Activity In Vitro of Medicinal Plants. Sky J. Microbiol. Res. 2013, 1, 5–21. [Google Scholar]
- Galovičová, L.; Čmiková, N.; Schwarzová, M.; Vukic, M.D.; Vukovic, N.L.; Kowalczewski, P.Ł.; Bakay, L.; Kluz, M.I.; Puchalski, C.; Obradovic, A.D.; et al. Biological Activity of Cupressus sempervirens Essential Oil. Plants 2023, 12, 1097. [Google Scholar] [CrossRef]
- Al-Rajhi, A.M.H.; Abelghany, T.M. Nanoemulsions of Some Edible Oils and Their Antimicrobial, Antioxidant, and Anti-hemolytic Activities. BioResources 2023, 18, 1465–1481. [Google Scholar] [CrossRef]
- Salman, A.A.; El-Aleem, A.; Ibrahim, M.; Rahman, A.E.; Ahmed, A.; Elhusseini, T.S.; El-Hadary, A.A.E. Protective Impacts of Cupressus sempervirens Leaves Extracts Against Paracetamol Hepatotoxicity. Benha Vet. Med. J. 2017, 32, 41–49. [Google Scholar] [CrossRef]
- Alam, M.A.; Subhan, N.; Rahman, M.M.; Uddin, S.J.; Reza, H.M.; Sarker, S.D. Sarker Effect of Citrus Flavonoids, Naringin and Naringenin, on Metabolic Syndrome and Their Mechanisms of Action. Adv. Nutr. 2014, 5, 404–417. [Google Scholar] [CrossRef] [PubMed]
- Atefeh, S.; Sorayya, G.; Solomon, H.; Shirin, A.; Zahra, L. Rutin: A Flavonoid as an Effective Sensitizer for Anticancer Therapy; Insights into Multifaceted Mechanisms and Applicability for Combination Therapy. Evid-Based Complement. Altern. Med. 2021, 2021, 9913179. [Google Scholar] [CrossRef]
- Srivastava, S.; Somasagara, R.; Hegde, M. Quercetin, a Natural Flavonoid Interacts with DNA, Arrests Cell Cycle and Causes Tumor Regression by Activating Mitochondrial Pathway of Apoptosis. Sci. Rep. 2016, 6, 24049. [Google Scholar] [CrossRef] [PubMed]
- Choi, J.H.; Kim, S. Investigation of the Anticoagulant and Antithrombotic Effects of Chlorogenic Acid. J. Biochem. Mol. Toxicol. 2017, 31, e21865. [Google Scholar] [CrossRef] [PubMed]
- Yongwang, Y.; Xu, Z.; Kangxiao, G.; Feng, Z.; Hongqi, Y. Use of Chlorogenic Acid Against Diabetes Mellitus and Its Complications. J. Immunol. Res. 2020, 2020, 9680508. [Google Scholar] [CrossRef]
- Alkhalidy, H.; Moore, W.; Zhang, Y.; McMillan, R.; Wang, A.; Ali, M.; Suh, K.S.; Zhen, W.; Cheng, Z.; Jia, Z.; et al. Small Molecule Kaempferol Promotes Insulin Sensitivity and Preserved Pancreatic β -Cell Mass in Middle-Aged Obese Diabetic Mice. J. Diabetes Res. 2015, 2015, 532984. [Google Scholar] [CrossRef]
- Sriti, J.; Haj Salem, M.; Aidi Wannes, W.; Bachrouch, O.; Mejri, H.; Belloumi, S.; Fares, N.; Jallouli, S.; Haoual-Hamdi, S.; Mediouni-Ben Jemâa, J.; et al. Antioxidant, Antibacterial and Insecticidal Activities of Cypress (Cupressus sempervirens L.) Essential Oil. Int. J. Environ. Health Res. 2023, 1–12. [Google Scholar] [CrossRef]
- Yazdani, S.; Doudi, M.; Rezayatmand, Z.; Rahimzadeh, T.L. Investigating the Antibacterial and Phytochemical Effect of Methanol and Acetone Extracts of the Cupressus sempervirens and Juniperus excelsa on Some Important Foodborne Diseases. J. Med. Herbs 2023, 14, 63–72. [Google Scholar]
- Ben Nouri, A.; Dhifi, W.; Bellili, S.; Ghazghazi, H.; Aouadhi, C.; Chérif, A.; Mnif, W. Chemical Composition, Antioxidant Potential, and Antibacterial Activity of Essential Oil Cones of Tunisian Cupressus sempervirens. J. Chem. 2015, 2015, 538929. [Google Scholar] [CrossRef]
- Ahmed, K.M. GC-MS, ICP-OES Analysis and Antioxidant Activity of Different Extracts of Leaves Part of Cupressus sempervirens L. cultivated in Kurdistan region—Iraq. J. Garmian Univ. 2017, 1, 542–560. [Google Scholar]
- Duh, P.D.; Tu, Y.Y.; Yen, G.C. Antioxidant Activity of Water Extract of Chyrsanthemum morifolium (Ramat.). Lebensm–Wiss. Technol. 1999, 32, 269–277. [Google Scholar] [CrossRef]
- Truscheit, E.; Frommer, W.; Junge, B.; Müller, L.; Schmidt, D.D.; Wingender, W. Chemistry and Biochemistry of Microbial α-Glucosidase Inhibitors. Angew. Chem. Int. Edit. 1981, 20, 744–761. [Google Scholar] [CrossRef]
- Shaki, F.; Habibi, E.; Parandavaji, M.; Ataee, R. Evaluation of Blood Sugar Lowering Effect of Airy Organs Extract of Cupressus sempervirens L. on Streptozocin Induced Diabetic Mice. SJKU 2019, 24, 52–65. [Google Scholar] [CrossRef]
- Abdel Ghany, T.M.; Ganash, M.; Alawlaqi, M.M. Antioxidant, Antitumor, Antimicrobial Activities Evaluation of Musa paradisiaca L. Pseudostem Exudate Cultivated in Saudi Arabia. BioNanoScience 2019, 9, 172–178. [Google Scholar] [CrossRef]
- Alghonaim, M.I.; Alsalamah, S.A.; Alsolami, A.; Abdelghany, T.M. Characterization and Efficiency of Ganoderma lucidum Biomass as an Antimicrobial and Anticancer Agent. BioResources 2023, 18, 8037–8061. [Google Scholar] [CrossRef]
- French, G.L. Bactericidal Agents in the Treatment of MRSA infections—The Potential Role of Daptomycin. J. Antimicrob. Chemother. 2006, 58, 1107. [Google Scholar] [CrossRef]
- Prieto, P.; Pineda, M.; Aguilar, M. Spectrophotometric Quantitation of Antioxidant Capacity through the Formation of a Phosphomolybdenum Complex: Specific Application to the Determination of Vitamin E. Anal. Biochem. 1999, 269, 337–341. [Google Scholar] [CrossRef]
- Lahmass, I.; Ouahhoud, S.; Elmansuri, M.; Sabouni, A.; Elyoubi, M.; Benabbas, R.; Choukri, M.; Saalaoui, E. Determination of Antioxidant Properties of Six By-products of Crocus sativus L.(Saffron) Plant Products. Waste Biomass Valorization 2018, 9, 1349–1357. [Google Scholar] [CrossRef]
- Benzie, I.F.; Strain, J.J. The Ferric Reducing Ability of Plasma (FRAP) as A Measure of Antioxidant Power: The FRAP assay. Anal. Biochem. 1996, 239, 70–76. [Google Scholar] [CrossRef]
- Athamena, S.; Laroui, S.; Bouzid, W.; Meziti, A. The Antioxidant, Anti-inflammatory, Analgesic and Antipyretic Activities of Juniperu thurifera. J. Herbs Spices Med. Plants 2019, 25, 271–286. [Google Scholar] [CrossRef]
- Pistia-Brueggeman, G.; Hollingsworth, R.I. A Preparation and Screening Strategy for Glycosidase Inhibitors. Tetrahedron 2001, 57, 8773–8778. [Google Scholar] [CrossRef]
- Wickramaratne, M.N.; Punchihewa, J.C.; Wickramaratne, D.B.M. In-Vitro Alpha Amylase Inhibitory Activity of The Leaf Extracts of Adenanthera pavonina. BMC Complement. Altern. Med. 2016, 16, 466. [Google Scholar] [CrossRef] [PubMed]
- Fana, L.; Wua, P.; Zhanga, J.; Gaoa, S.; Wanga, L.; Li, M.; Shaa, M.; Xieb, W.; Niec, M. Synthesis and Anticoagulant Activity of The Quaternary Ammonium Chitosan Sulfates. Int. J. Biol. Macromol. 2012, 50, 31–37. [Google Scholar] [CrossRef] [PubMed]
Disclaimer/Publisher’s Note: The statements, opinions and data contained in all publications are solely those of the individual author(s) and contributor(s) and not of MDPI and/or the editor(s). MDPI and/or the editor(s) disclaim responsibility for any injury to people or property resulting from any ideas, methods, instructions or products referred to in the content. |
© 2023 by the authors. Licensee MDPI, Basel, Switzerland. This article is an open access article distributed under the terms and conditions of the Creative Commons Attribution (CC BY) license (https://creativecommons.org/licenses/by/4.0/).